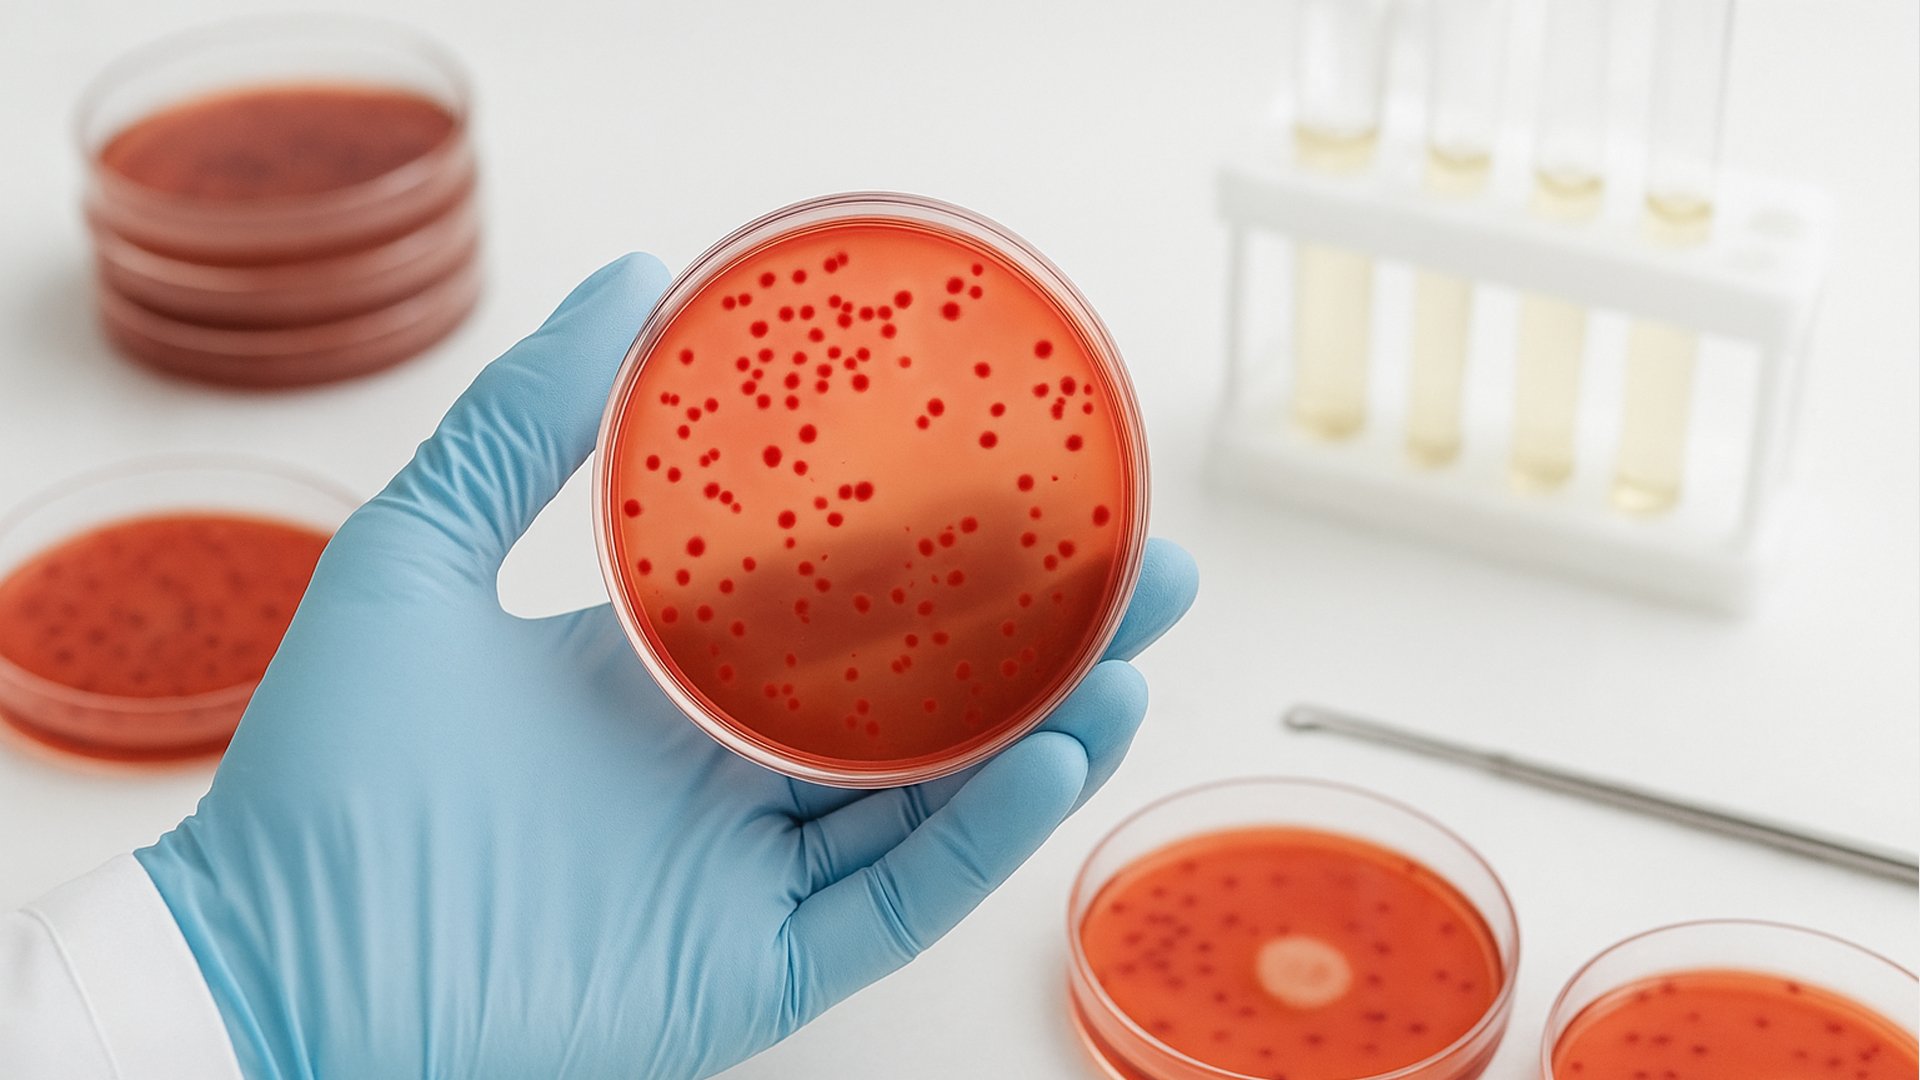
Meios de cultura utilizados em placas de Petri no laboratório

Os meios de cultura são preparações químicas fundamentais em laboratórios, pois fornecem os nutrientes necessários para que microrganismos como bactérias, leveduras e fungos possam crescer. Dessa forma, é possível estudar, identificar e analisar organismos de forma controlada e segura.
Além disso, cada microrganismo possui necessidades específicas. Portanto, compreender as diferenças entre os meios de cultura é indispensável para garantir análises confiáveis e resultados de alta precisão.
O que são Meios de Cultura?
Em termos simples, os meios de cultura funcionam como um ambiente nutritivo necessário para o crescimento de microrganismos. Assim, eles podem desempenhar diferentes funções:
- Nutrir e estimular o crescimento;
- Inibir organismos indesejados;
- Indicar parâmetros como o pH do meio.
De forma geral, são compostos por carbono, fósforo, energia, sais minerais e nitrogênio. No entanto, cada meio é desenvolvido para uma finalidade específica.
Etapas do Processo Laboratorial
O preparo e uso dos meios de cultura envolvem etapas fundamentais, que garantem precisão e segurança. Por isso, cada fase precisa ser cuidadosamente executada:
- Meio de cultura: base nutritiva onde ocorre o crescimento microbiano;
- Inóculo: introdução do microrganismo no meio preparado;
- Cultura: multiplicação do organismo inoculado;
- Placa de Petri: recipiente estéril para acondicionamento;
- Ágar: substância em gel que auxilia no crescimento;
- Alças de inoculação: instrumento utilizado para evitar contaminações.
Dessa forma, todo o processo laboratorial se torna eficiente, seguro e confiável.
Classificação dos Meios de Cultura
Os meios de cultura podem ser classificados tanto pela sua constituição quanto pela sua finalidade. Logo, é possível dividi-los da seguinte maneira:
-
Meios quimicamente definidos e complexos
- Definidos: possuem composição totalmente conhecida;
- Complexos: incluem extratos naturais de leveduras, vegetais ou animais.
-
Tipos físicos
- Líquidos: geralmente em tubos de ensaio;
- Semissólidos e sólidos: preparados com ágar, em tubos ou placas de Petri.
-
Meios específicos
- Enriquecidos: com nutrientes extras para microrganismos exigentes;
- Seletivos: favorecem o crescimento de organismos específicos, inibindo outros;
- Diferenciais: permitem distinguir microrganismos com base em suas características visíveis.
A importância dos Meios de Cultura
Os meios de cultura vão além da microbiologia básica. Na prática, eles são indispensáveis em diversas áreas. Por exemplo:
- Laboratórios clínicos: permitem isolar patógenos em amostras;
- Indústria farmacêutica: viabilizam o desenvolvimento de antibióticos e vacinas;
- Engenharia genética e alimentos: utilizados na produção de bebidas, derivados e probióticos.
Portanto, os meios de cultura representam um elo essencial entre ciência, saúde e indústria.
Conclusão
Os meios de cultura são verdadeiros pilares da microbiologia. Eles possibilitam o crescimento, a análise e a diferenciação de microrganismos com alta precisão. Em síntese, conhecer suas classificações e aplicações é indispensável para qualquer profissional da área científica.
Por fim, na TERATEC oferecemos suporte especializado para que laboratórios mantenham a qualidade e a confiabilidade em suas análises. Entre em contato e saiba mais.
VoltarCom a Teratec você conta comServiços Completos

Reparo, Calibração eManutenção de Microscópios
Serviço completo de manutenção, com etapas detalhadas que garantem a revisão completa de todos os sistemas do seu microscópio.

Manutenção eCalibração de Micropipetas
Manutenção e calibração de micropipetas, com Rastreabilidade RBC e conformidade com as Normas ISO 8655 e ISO 17025.

Experimente nossaAssistência Técnica Oficial
Equipe certificada para manutenção e reparos, garantindo conformidade com os padrões de desempenho e segurança dos fabricantes.

Aprimore seu Laboratório comConsultoria e Treinamentos
Consultoria especializada e treinamentos personalizados para te auxiliar na escolha dos melhores equipamentos e soluções.
Produtos paraLaboratórios
Ampla gama de equipamentos e acessórios laboratoriais de alta qualidade, selecionados para atender às suas necessidades específicas.
Atendemos todasMarcas e Modelos



















